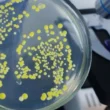

جدول المحتويات
- فوائد البوتاسيوم الصحية
- فعالية البوتاسيوم في علاج الأمراض
- مخاطر الإفراط في استهلاك البوتاسيوم
- الكميات الموصى بها من البوتاسيوم
- أسئلة شائعة حول البوتاسيوم
- نظرة عامة على البوتاسيوم
- المراجع
اكتشاف الفوائد الصحية للبوتاسيوم
يُعتبر البوتاسيوم عنصراً غذائياً أساسياً له دور حيوي في العديد من الوظائف الحيوية للجسم. فهو يساعد على تنظيم ضغط الدم، ويساهم في عمل العضلات والأعصاب، ويُسهم في الحفاظ على توازن السوائل داخل الجسم. يُعدّ البوتاسيوم ضرورياً للحفاظ على صحة القلب، ويمكن أن يُساعد في الوقاية من بعض الأمراض المزمنة.
فعالية البوتاسيوم في علاج الأمراض
تُصنف فوائد البوتاسيوم حسب درجة فعاليتها العلمية المتوفرة:
- فعال (Effective): علاج نقص البوتاسيوم في الدم (Hypokalemia)، حيث يُنصح باستهلاك البوتاسيوم عن طريق الفم أو الوريد لتجنب المضاعفات الخطيرة.
- غالباً فعال (Likely Effective): المساعدة في خفض ضغط الدم، خاصةً عند زيادة استهلاك الفواكه والخضروات الغنية بالبوتاسيوم، أو من خلال المكملات الغذائية تحت إشراف طبي.
- احتمالية فعاليته (Possibly Effective): تقليل خطر الإصابة بالجلطة الدماغية، حيث تُشير بعض الدراسات إلى وجود علاقة إيجابية بين استهلاك البوتاسيوم والوقاية من الجلطة، لكن لا تزال هناك حاجة إلى المزيد من البحث.
- لا توجد أدلة كافية على فعاليته (Insufficient Evidence): هناك عديد من الحالات الصحية التي يُعتقد أن البوتاسيوم قد يُفيد فيها، مثل مقاومة الإنسولين، لكن الأدلة العلمية غير كافية لتأكيد ذلك.
المخاطر المحتملة عند استهلاك البوتاسيوم
على الرغم من فوائد البوتاسيوم العديدة، إلا أن الإفراط في تناوله قد يُسبب بعض المشاكل الصحية، وخاصةً لذوي الأمراض الكلوية. يُنصح بالتقيد بالكميات الموصى بها من البوتاسيوم لتجنب الآثار الجانبية، مثل الغثيان، الإسهال، وعدم انتظام ضربات القلب. يُعدّ البوتاسيوم آمناً بالنسبة لمعظم الأشخاص عند تناوله بالكميات المعتدلة، ولكن يُنصح باستشارة الطبيب قبل تناول مكملات البوتاسيوم.
كمية البوتاسيوم اللازمة للجسم
تختلف الكمية الموصى بها من البوتاسيوم حسب العمر والفئات السكانية. يُرجى الرجوع إلى الطبيب أو أخصائي التغذية لتحديد الكمية المناسبة لك.
| الفئة العمرية | الكمية الموصى بها (مليغرام/يوم) |
|---|---|
| الرضع (0-6 أشهر) | 400 |
| الرضع (7-12 شهر) | 860 |
| الذكور (19-50 سنة) | 3400 |
| الإناث (19-50 سنة) | 2600 |
إجابات على بعض التساؤلات الشائعة
هل هناك أطعمة خالية من البوتاسيوم؟ بعض الأطعمة تحتوي على كميات ضئيلة جداً من البوتاسيوم، مثل الزيوت المكررة.
هل تحتوي الفواكه على البوتاسيوم؟ نعم، العديد من الفواكه غنية بالبوتاسيوم، مثل الموز، البرتقال، والشمام.
ما هي أملاح البوتاسيوم وفوائدها؟ أملاح البوتاسيوم تُستخدم كبديل لأملاح الصوديوم، وتُساعد في تزويد الجسم بالبوتاسيوم، ولكن يجب الحذر لأصحاب أمراض الكلى.
البوتاسيوم: دوره الأساسي في الحفاظ على الصحة
يُعدّ البوتاسيوم معدنًا هامًا لصحة الجسم، فهو يدخل في العديد من العمليات الحيوية، ويُحافظ على توازن السوائل، ويساعد في عمل القلب والعضلات. يُنصح بإدراج الأطعمة الغنية بالبوتاسيوم في النظام الغذائي لضمان الحصول على الكميات الكافية منه. الكميات المنخفضة أو العالية من البوتاسيوم قد تكون ضارة، لذا يُنصح بالتوازن.
المصادر
سيتم إضافة المراجع هنا.